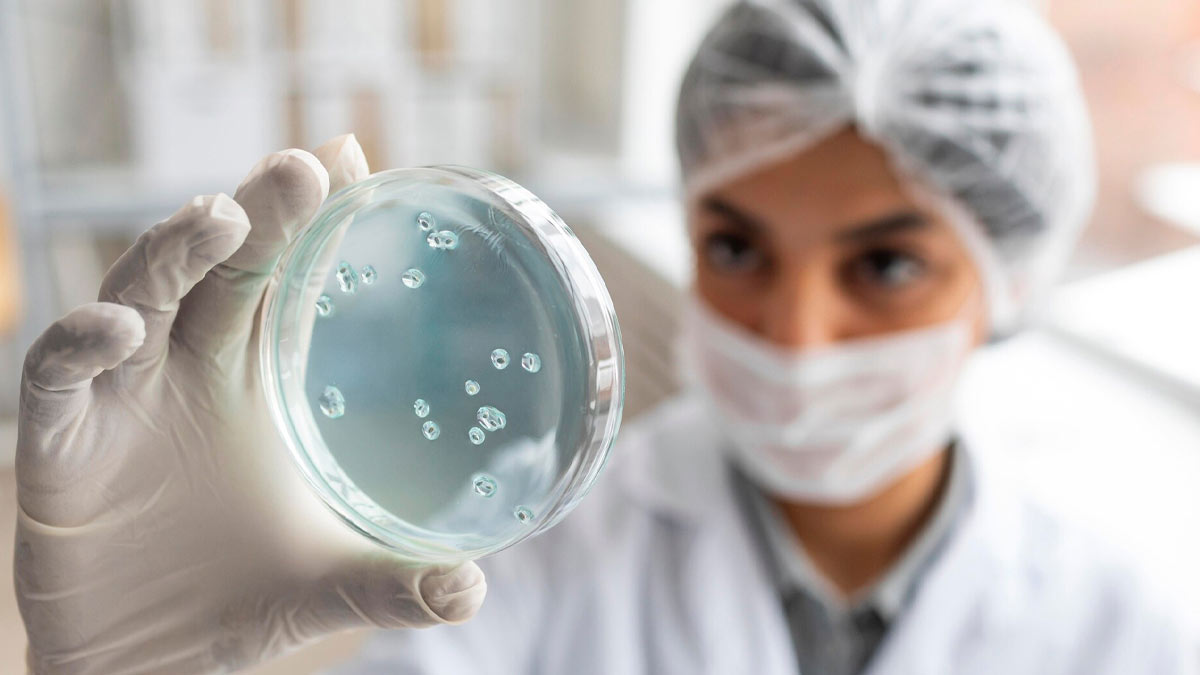
what is stem cell preservation benefits

आज के वैज्ञानिक युग में कई असाध्य मानी जाने वाली बीमारियों के इलाज के लिए अब ऐसी तकनीकों का विकास हो चुका है, जो पहले सिर्फ सपना लगती थीं। इन्हीं में से एक है स्टेम सेल प्रिजर्वेशन, जिसे अब माता-पिता नवजात शिशुओं के जन्म के साथ ही अपनाने लगे हैं। स्टेम सेल्स शरीर की वह विशेष कोशिकाएं होती हैं, जो किसी भी प्रकार की कोशिका में बदलने की क्षमता रखती हैं। यही कारण है कि इनका उपयोग कई गंभीर और लाइलाज बीमारियों के इलाज में किया जा सकता है, जैसे ल्यूकीमिया (blood cancer), स्पाइनल कोर्ड इंजरी, न्यूरोलॉजिकल डिसऑर्डर और कुछ ऑटोइम्यून डिजीज। इस लेख में जयपुर के दिवा अस्पताल और आईवीएफ केंद्र की प्रसूति एवं स्त्री रोग की विशेषज्ञ, लेप्रोस्कोपिक सर्जन और आईवीएफ विशेषज्ञ डॉ. शिखा गुप्ता (Dr. shikha gupta, Laparoscopic surgeon and IVF specialist, DIVA hospital and IVF centre) से जानिए, स्टेम सेल प्रिजर्वेशन क्या है और इसके क्या-क्या फायदे हो सकते हैं।
स्टेम सेल प्रिजर्वेशन क्या है? - What is stem cell preservation
आईवीएफ विशेषज्ञ डॉ. शिखा गुप्ता बताती हैं कि स्टेम सेल प्रिजर्वेशन का सबसे सामान्य तरीका है नवजात शिशु के जन्म के समय उसकी अम्बिलिकल कॉर्ड (नाल) से रक्त लेकर उसमें मौजूद स्टेम सेल्स को संग्रहित करना। यह एक सरल, सुरक्षित और दर्द रहित प्रक्रिया है, जो मां या शिशु को कोई नुकसान नहीं पहुंचाती। आज भारत में कई निजी और सार्वजनिक स्टेम सेल बैंक हैं, जो इस तरह की सेवाएं प्रदान कर रहे हैं। हालांकि, इसके बारे में अब भी कई लोगों को जानकारी नहीं है या फिर वे इसे लेकर संकोच या भ्रम में रहते हैं।
इसे भी पढ़ें: ब्लड कैंसर के मरीजों के लिए रामबाण है स्टेम सेल ट्रांसप्लांट, जानें इससे जुड़ी जरूरी बातें
स्टेम सेल कैसे और कब ली जाती हैं?
- सबसे आम तरीका है नवजात शिशु के जन्म के समय अम्बिलिकल कॉर्ड ब्लड (नाल में मौजूद रक्त) से स्टेम सेल्स निकालना।
- बच्चे या माँ को कोई नुकसान नहीं पहुंचता।
- जन्म के तुरंत बाद कॉर्ड को काटने से पहले या तुरंत बाद किया जाता है।
- खून को विशेष किट में संग्रहित कर, स्टेम सेल्स को प्रोसेस करके क्रायो-प्रिजर्वेशन तकनीक से -196°C पर संग्रहित किया जाता है।
- इस प्रक्रिया के लिए माता-पिता को बच्चे के जन्म से पहले ही किसी स्टेम सेल बैंक से संपर्क करना होता है।
इसे भी पढ़ें: अब बिना सर्जरी के ठीक हो सकेगी मांसपेशियों की गहरी चोट, टेंडन स्टेम सेल्स से हीलिंग में मिलेगी मदद
स्टेम सेल प्रिजर्वेशन के फायदे - Benefits of stem cell preservation
1. बीमारियों से सुरक्षा
बचपन में सुरक्षित किए गए स्टेम सेल्स भविष्य में किसी भी गंभीर बीमारी के इलाज में काम आ सकते हैं। यह जीवन बचाने वाला कदम हो सकता है।
2. परिवार के अन्य सदस्यों को भी फायदा
अगर स्टेम सेल मैच हो जाएं, तो ये भाई-बहन या माता-पिता के इलाज में भी काम आ सकती हैं। खासकर ब्लड कैंसर या जेनेटिक डिसऑर्डर्स में।
3. रिजेक्शन की संभावना कम
अपने शरीर की कोशिकाएं होने के कारण, स्टेम सेल थैरेपी में रिजेक्शन की संभावना बहुत कम होती है।
निष्कर्ष
स्टेम सेल प्रिजर्वेशन भविष्य की कई बीमारियों के इलाज में सहायक हो सकता है। हालांकि अभी भी इस पर काफी रिसर्च जारी है, लेकिन इसके संभावित फायदे इसे एक जरूरी विकल्प बनाते हैं।
All Images Credit- Freepik
How we keep this article up to date:
We work with experts and keep a close eye on the latest in health and wellness. Whenever there is a new research or helpful information, we update our articles with accurate and useful advice.
Current Version